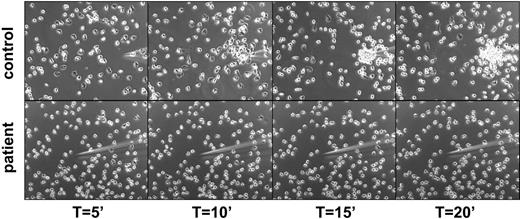
Figure 3. Lack of polarization and chemotaxis of purified neutrophils toward a micropipette from which an optimal dose of fMLP is diffusing in a prewarmed chamber containing healthy control cells (top panel) or patients' cells (bottom panel). Representative for 4 patients.

Abstract
The syndrome of leukocyte adhesion deficiency (LAD) combined with a severe Glanzmann-type bleeding disorder has been recognized as a separate disease entity. The variability in clinical and cell biological terms has remained largely unclear. We present data on 9 cases from 7 unrelated families, with 3 patients being actively followed for more than 12 years. The disease entity, designated LAD-1/variant syndrome, presents early in life and consists of nonpussing infections from bacterial and fungal origin, as well as a severe bleeding tendency. This is compatible with 2 major blood cell types contributing to the clinical symptoms (ie, granulocytes and platelets). In granulocytes of the patients, we found adhesion and chemotaxis defects, as well as a defect in NADPH oxidase activity triggered by unopsonized zymosan. This last test can be used as a screening test for the syndrome. Many proteins and genes involved in adhesion and signaling, including small GTPases such as Rap1 and Rap2 as well as the major Rap activity-regulating molecules, were normally present. Moreover, Rap1 activation was intact in patients' blood cells. Defining the primary defect awaits genetic linkage analysis, which may be greatly helped by a more precise understanding and awareness of the disease combined with the early identification of affected patients.
Introduction
The leukocyte adhesion deficiency 1 (LAD-1)/variant syndrome as described in 1997 consists of 2 major hallmarks: a moderate LAD-1–like syndrome and a severe Glanzmann-like bleeding tendency.1 To date, 3 similar patients have been reported in addition.2-4 The complex of clinical features is predominantly related to a neutrophil defect and platelet dysfunction.
Leukocytes and platelets in these patients have a normal level of integrin expression, but these integrins do not function properly. In vitro, the absence of chemotaxis toward all chemoattractant stimuli tested and the lack of adhesion to substrates (in contrast to lymphocytes) were noted, but were not due to the absence of any of the 7-transmembrane spanning G-protein–coupled receptors (GPCRs) involved in cell activation, nor to a defect in any of the known signaling cascades transducing the signals via mitogen-activated protein kinase (p38MAPK, ERK1, and ERK2), phospholipase-C (PLC), or phosphatidyl-inositol-3 kinase (PI3K) to effector functions. Mobilization of intracellular calcium, polymerization of F-actin, release of proteins from azurophil and specific granules, and the induction of NADPH-oxidase activity in neutrophils were found normal. The same is true for the platelets in the patients, because effector functions induced by the platelets were intact as long as the β3 integrin activation was not a determinant step in the process1 (T.W.K., unpublished data, March and May 2004, February and October 2005, and January 2006).
A general integrin-associated defect or intracellular signaling defect has not yet been identified in these patients. Of interest, Alon and colleagues have suggested that the syndrome is caused by an aberrant activation of Rap1 in these patients (Alon et al4 and Kinashi et al5 ). The small GTPase Rap1 belongs to the large Ras family of GTPases and is involved in several aspects of cell adhesion, including integrin-mediated cell adhesion and cadherin-mediated cell junction formation. To date, various effector proteins for Rap1 have been identified, providing a clear link between Rap1 and actin dynamics. Furthermore, evidence is accumulating that Rap1 functions in spatial and temporal control of cell polarity.6-9 Similar to all other small GTPases, Rap1 binds either GDP or GTP, and the change between these 2 states represents a molecular switch (ie, the GTP-bound form is “on” and the GDP-bound form is “off”).6,10,11 The GDP/GTP exchange is regulated by tissue- and cell-specific guanine nucleotide exchange factors (GEFs) and GTPase-activating proteins (GAPs).12-16
Over the last years, we have obtained many data on these pathways that do not favor a defect in Rap activation in the leukocytes of several patients with LAD-1/variant syndrome. In this paper, we describe in more detail our present findings on Rap-1 activity. Although we cannot exclude the existence of several genetic defects resulting in a similar phenotype, every claim about the diagnosis of a so-called LAD-variant syndrome will be determined by the sensitivity and reproducibility of a test with which the syndrome can be diagnosed. Instead of using monoclonal antibodies (MoAbs) to detect activation epitopes on integrin subunits,1 we now show that the syndrome can be best defined by a simple and robust screening test. The advantage of the screening test with unopsonized zymosan particles derived from baker's yeast will mean a large diagnostic improvement. In the presence of normal β2 integrin expression levels on all leukocytes, normal up-regulation of these integrins upon activation on neutrophils, but abnormal neutrophil chemotaxis, the zymosan test discriminates the functional defect of such patients easily and without failure.
Now that we have identified over the years more of such patients, a clinical picture of the syndrome can also be delineated. To give direction to the eventual elucidation of the genetic background of the LAD-1/variant syndrome, we describe in this paper the natural history of 9 patients from 7 unrelated families. In addition, we demonstrate that Rap1 activation is not the principal defect in this syndrome. And, finally, we describe a simple and robust screening assay to diagnose the patients.
Patients, materials, and methods
Neutrophil, lymphocyte, and platelet purification
Heparinized venous blood was collected from healthy donors and from LAD-1/variant patients and their family members, after obtaining informed consent. The study was approved by the AMC institutional medical ethics committee in accordance with the standards laid down in the 1964 Declaration of Helsinki.
Granulocytes were isolated as described.17,18 Purity was always more than 95%. In some experiments, whole leukocyte preparations were used from which the erythrocytes were lysed by ice-cold isotonic NH4Cl solution17 and resuspended in HEPES buffer for further experiments.18
After Percoll density gradient centrifugation of the blood, peripheral blood mononuclear leukocytes were collected from the interface. Monocytes were depleted by an adhesion step to plastic for 60 minutes in RPMI 1640 (Gibco, Grand Island, NY) at 37°C. Mixed lymphocytes were resuspended in RPMI 1640 (Gibco) at a final concentration of 20 × 106 cells/mL.
Platelets were isolated from platelet-rich plasma diluted in Krebs-Ringer solution (4 mM KCl, 107 mM NaCl, 20 mM NaHCO3, 2 mM Na2SO4, 19 mM trisodium citrate, 0.5% [wt/vol] glucose in H2O, pH 5.0). After centrifugation at 500g for 10 minutes, the cells were resuspended in Krebs-Ringer solution (pH 6.0) and centrifuged again at 500g for 10 minutes. After 2 additional washing steps, the cells were suspended in Hepes/Tyrode buffer (2.68 mM KCl, 10 mM Hepes, 1.7 mM MgCl2, 11.9 mM NaHCO3, 5 mM glucose in PBS) to a concentration of 200 × 106 cells/mL.
Neutrophil migration and adhesion
Chemotaxis of purified neutrophils was assessed by means of Fluoroblok inserts (Falcon; Becton Dickinson, San Jose, CA). Cells (5 × 106/mL) were labeled with calcein-AM (1 μM final concentration; Molecular Probes, Leiden, the Netherlands) for 30 minutes at 37°C, washed twice, and resuspended in HEPES buffer at a concentration of 2 × 106/mL. Chemoattractant solution (PAF, IL-8, and C5a, all at 10 nM; Sigma, St Louis, MO) or medium alone (0.8 mL/well) was placed in a 24-well plate, and 0.3 mL cell suspension was delivered to the inserts (3-μm pore size) and placed in the 24-well plate. Cell migration was assessed by measuring fluorescence in the lower compartment at 2.5-minute intervals for 45 minutes with the HTS7000+ plate reader (Perkin Elmer, Norwalk, CT) at an excitation wavelength of 485 nm and emission wavelength of 535 nm. Maximal slope of migration was estimated over a 10-minute interval.19
Adhesion was determined in 96-well maxisorp plates (Nunc, Wiesbaden, Germany), precoated or not with human plasma-derived fibronectin for 60 minutes at room temperature. Calcein-labeled cells (100 μL; 2 × 106/mL) were pipetted in the 96-well plate, and cells were stimulated with 25 μL solvent with PAF (final concentration, 1 μM), TNF (final concentration, 10 ng/mL), or PMA (final concentration, 100 ng/mL) as stimulus. Plates were incubated for 30 minutes at 37°C. Thereafter, the plates were washed 3 times with PBS at room temperature. Adherent cells were lysed with 125 μL H2O, containing 0.5% (wt/vol) Triton X-100 (10 minutes, room temperature). Fluorescence was measured with the HTS7000+ plate reader at an excitation wavelength of 485 nm and emission wavelength of 535 nm. Adhesion was determined as a percentage of total cell input (2 × 106/mL).
Analysis of neutrophil chemotaxis in the micropipette assay
Neutrophils (5 × 105) in HEPES buffer were allowed to adhere for 10 minutes to glass slides precoated with ICAM-1-Fc chimera (a generous gift of Dr D. Staunton, ICOS, Bethell, WA). Chemotaxis toward a micropipette tip (Eppendorf Pipetman, Hamburg, Germany) containing 10−9 M C5a was then visualized using an Axiovert 200M microscope (Zeiss, Jena, Germany) equipped with an LD Achroplan 20×/0.40 numerical aperture objective. Images were taken using an Axiocam MRm with Axiovision version 4.5 software. The software used for image processing was Image-Pro Ams version 6 (Media Cybernetics, Silver Spring, MD).
Induction of NADPH-oxidase activity
NADPH-oxidase activity was assessed as hydrogen peroxide release determined by an Amplex Red kit (Molecular Probes). Neutrophils (0.25 × 106/mL) were stimulated with PAF and fMLP (both 1 μM, added simultaneously), 1 mg/mL STZ, or 100 ng/mL PMA, in the presence of Amplex Red (0.5 μM) and horseradish peroxidase (1 U/mL). Fluorescence was measured at 30-second intervals for 20 minutes with the HTS7000+ plate reader. Maximal slope of H2O2 release was assessed over a 2-minute interval.19,20
Using unopsonized zymosan, the same steps and procedures were followed, but fluorescence was measured for 60 minutes at similar 30-second intervals. Maximal slope of H2O2 release was assessed over a 2-minute interval.
In order to exclude cell death during blood transportation or improper handling, control experiments were performed for annexin-V binding, mitochondrial staining, and morphology, exactly as described.21,22 Morphology was determined after Giemsa staining of cytospin preparations. Apoptotic morphology was defined as the presence of condensed nuclei and simultaneous loss of the polysegmented nuclear appearance.
Rap activation assay
Rap1 activation was determined essentially as described.23 After warming the cell suspensions, neutrophils (10 × 106 cells/mL), lymphocytes (20 × 106 cells/mL), or platelets (200 × 106 cells/mL) were stimulated with the relevant stimuli or buffer alone: that is, TRAP-6 (thrombin-receptor-derived activation peptide-6; Bachem, Bubendorf, Switzerland) at 10 μM, human SDF1α-10a (Strathmann Biotec, Hamburg, Germany) at 12.5 nM, and PAF and fMLP (both from Sigma) at 1 μM final concentration.
At various time points, samples (0.5 mL) were taken and lysed immediately in 250 μL ice-cold modified RIPA (3 ×) buffer containing 30 mM Tris-HCl (pH 7.4), 450 mM NaCl, 3% NP-40, 1.5% deoxycholic acid, 0.3% SDS, and a mixture of protease inhibitors (Complete EDTA-free; Roche, Basel, Switzerland) and DFP (Fluka Gmb, Seelze, Germany).
Cell lysates were put on ice for 10 minutes and clarified by centrifugation at 20 000g in an Eppendorf centrifuge for 10 minutes at 4°C. Per sample, 15 μg glutathione S-transferase (GST)–RalGDS-RBD was precoupled for 1 hour to 20 μL glutathione beads (GST-RalGDS-RBD). After coupling, beads were washed 4 times with RIPA (1 ×) buffer, added to the cell lysate, and incubated for 60 minutes at 4°C. Samples were washed 3 times in RIPA (1 ×) buffer, and bound proteins were eluted in 30 μL Laemmli sample buffer. The samples were subjected to SDS–polyacrylamide gel electrophoresis (SDS-PAGE) and transferred to polyvinylidene difluoride membranes (PVDF; NEN, Boston, MA). Rap1 was detected with a monoclonal antibody (Transduction Laboratories, Lexington, KY) and horseradish peroxidase–coupled goat anti–mouse Ig (Amersham Biosciences, Buckingham, United Kingdom), using enhanced chemiluminescence (Amersham Biosciences). Western blot of total cell lysates served as a control for equal input into the Rap-binding domain affinity purification. In some experiments, Rap2 antibodies (Santa Cruz Biotechnology, Santa Cruz, CA) were used instead.
Molecular studies
Genomic DNA from peripheral mononuclear cells and fibroblasts from the patients were extracted by standard methods. All coding exons of the CD18 gene were amplified in separate polymerase chain reactions (PCRs).1,24 Sequencing was performed with the PE dye terminator kit and products were analyzed on an automated sequencer (ABI3100; Applied Biosystems, Foster City, CA).
Hematologic studies
Morphologic analysis demonstrated hypercellular bone marrow (BM) in most of the BM smears, in some patients confirmed by BM biopsies. No excess of collagen or signs of fibrosis, disturbed bone marrow stroma development, or disorganized hematopoiesis were observed. In some patients, absolute numbers of progenitor B cells (CD19+, CD10+, CD24+), T cells (CD2+, CD3+, CD4+, CD8+), natural killer (NK) cells (CD3−, CD16+, CD56+), and myeloid cells (CD15+, CD14+, CD16+, CD65+) were determined by standard FACScan procedures. Colony-forming units of the erythroid and granulocyte/macrophage progenitors (BFU-Es and CFU-GMs, respectively) were determined in a 10- to 14-day semisolid culture.
Cytogenetic analysis
Freshly obtained bone marrow samples were collected, cultured (without stimulation) in RPMI-1640 supplemented with 15% (wt/vol) fetal calf serum for 24 hours, and harvested according to standard protocols. PHA-stimulated peripheral blood lymphocytes were cultured for 72 hours. Metaphase chromosomes were analyzed with a routine Q-banding method (QFA) and abnormal clones were defined according to the International System for Human Cytogenetic Nomenclature 18, as described earlier.20
Statistics
Statistical analysis was performed with the SPSS package for windows, version 10.0 (SPSS, Chicago, IL). For normally distributed data, the Student t test was used to compare group means; otherwise the Mann-Whitney U test was applied. A 2-sided P value of less than .05 was considered statistically significant.
Results
Clinical features
We identified 7 families with 9 members suffering from LAD-1/variant syndrome (Figure 1), including the original family described in 1997.1 All these families are known for their consanguineous offspring, and all members are descendants of Turkish ancestors from Anatolia, a region in central Turkey, although most of the patients were born in Europe. Nonpussing infections and severe bleedings are the apparent early and repeatedly recurring findings in these patients (Table 1). Patients diagnosed with the classical LAD-1 defect caused by mutations in the ITG2 gene, show late detachment of the umbilical cord.24-26 In the LAD-1/variant syndrome, the umbilical cord detached after 4 weeks in (at least) 3 of the children. Omphalitis was noted in 2 patients during the neonatal period and treated by antibiotics; in 1 of these 2 patients, information confirmed late detachment of the umbilical cord. Cultures did not show any particular pathogen involved. The omphalitis never resulted in necrotizing lesions or necessitated surgical intervention.
Pedigrees of 7 unrelated families with LAD-1/variant syndrome patients. The diamonds in families 2, 3, and 7 denote stillbirths after a pregnancy of a duration in weeks as indicated beneath the genetic symbols used.
Pedigrees of 7 unrelated families with LAD-1/variant syndrome patients. The diamonds in families 2, 3, and 7 denote stillbirths after a pregnancy of a duration in weeks as indicated beneath the genetic symbols used.
The infectious agents cultured were mostly Gram-negative strains causing early sepsis (eg, Escherichia coli, Pseudomonas spp), but staphylococcal infections were found as well. Fungal disease occurred in 3 patients, one with superficial skin infections and assumed mediastinal lymph node involvement (family 1), one with pulmonary Aspergillus fumigatus infection as proven by bronchoalveolar lavage after treatment with multiple antibiotics for chronic bilateral pulmonary infiltrates (family 3), and another with Fusarium oxysporum infection of the blood and the simultaneous presence of painful subcutaneous nodules (family 4). In the first case, voriconazole was administered for 8 weeks to treat the mediastinal mass. The proven pulmonary aspergillosis in the 6-month-old patient of family 3 was successfully treated with intravenous amphotericin B. In the patient of family 4 at 2 years of age, the fusariosis was treated with lipid-formulated amphotericin B for 12 weeks, combined with flucytosine for the first 4 weeks; the infected Port-a-Cath was removed. Some patients had been immunized very early in life by the attenuated bacillus Calmette Guérin (BCG) vaccine strain, without any infectious consequence.
In 2 patients, CMV infection was diagnosed by CMV-specific PCR, serology, and cultures from the urine, but in both cases the disease was not severe. Overall, there was no evidence for increased susceptibility to viral infections. No indications for congenital CMV were found (negative virus cultures in the first 14 days of life; lack of clinical stigmata such as microcephaly, vision impairment, or neuronal deafness upon follow-up).
Splenomegaly or hepatosplenomegaly was observed in almost all patients, in some only later during infancy, which may result from extramedullary hematopoiesis.
Three children with the syndrome were born with mulberry spots and in one child extramedullary hematopoiesis was proven by skin biopsy (data not shown).
Patients from families 4, 5, and 6 were suspected of presumed juvenile myelomonocytic leukemia (JMML). All patients were tested in one way or another for the differential diagnosis of JMML. Granulocyte-macrophage colony-stimulating factor (GM-CSF) hypersensitivity of bone marrow (BM) or blood cells, as the hallmark for JMML,27 was negative. Moreover, the thrombasthenia was present in all patients, being another feature to distinguish JMML from LAD-1/variant syndrome. Hematologic malignancy or solid tumors have not been noted in any of the patients thus far.
Our index patient from family 1 showed the unexpected potential to form thrombosis. He was admitted because of clinical vena cava superior syndrome owing to occlusion of the subclavian veins and the right-sided vena jugularis communis by phlebography, most likely as a result of the repeated platelet infusions in the presence of an indwelling Port-a-Cath (which he had for more than 8 years without any problem). A well-prepared mediastinal biopsy of an enlarged lymph node resulted in a severe bleeding (despite optimizing platelet function by prior transfusions and a thoracoscopic approach); the procedure ended in an iatrogenic hematothorax. The patient was in the intensive care unit for respiratory failure and bilateral pneumonia and septicemia by Pseudomonas aeruginosa, for which he was treated with antibiotics. In addition, this patient received 4 granulocyte transfusions. The boy survived and subsequently, at the age of 13 years, successfully received a bone marrow transplant from a matched unrelated donor. Although we have not formally proven that the donor-derived neutrophils have tilted the balance into a favorable condition of pathogen clearance and initiation of wound healing, we strongly believe that the patient was saved by these transfusions.
In family 4, the eldest son (born in 1992) died from P aeruginosa septicemia following surgical débridement of a deep and necrotic wound on his thigh after initial resolution with granulocyte transfusions at the age of 13 years. These transfusions have not been administered during or around the surgical approach chosen. The youngest son in this family died from a severe nose bleed after a trauma at the age of 6 years.
The 13-year-old female twin sisters of family 6 are relatively healthy. One has started menstruation. Contraceptives are being used to regulate the frequency of bleeding, which until now could be controlled with single platelet transfusions.
Neutrophil chemotaxis and adhesion defects; normal Rap 1 activation
Adhesion was defined in uncoated wells or in wells coated with fibronectin. Under all circumstances, the stimuli tested most often induced weak adhesion, in contrast to purified neutrophils from healthy controls (Figure 2A). Neutrophil chemotaxis was measured and found defective in all patients tested (n = 7; Figure 2B).
Neutrophil adhesion and chemotaxis in LAD-1/variant syndrome. (A) Neutrophil adhesion to fibronectin upon activation by various stimuli (n = 7 patients). Neutrophils were isolated from blood of (local) healthy individuals shipped in the same manner and are included as controls. (B) Neutrophil chemotaxis to various chemotactic factors. Data of 7 patients have been combined. Controls as in panel A. Data represents mean ± SD.
Neutrophil adhesion and chemotaxis in LAD-1/variant syndrome. (A) Neutrophil adhesion to fibronectin upon activation by various stimuli (n = 7 patients). Neutrophils were isolated from blood of (local) healthy individuals shipped in the same manner and are included as controls. (B) Neutrophil chemotaxis to various chemotactic factors. Data of 7 patients have been combined. Controls as in panel A. Data represents mean ± SD.
The severely reduced ability to invoke some directed motility seemed due to the lack of polarization and attachment sites generated by the neutrophils, as shown in an assay of directed migration toward a gradient of chemoattractant from a micropipette (Figure 3 and Videos S1–S2, which are available on the Blood website; see the Supplemental Videos link at the top of the online article).
Lack of polarization and chemotaxis of purified neutrophils toward a micropipette from which an optimal dose of fMLP is diffusing in a prewarmed chamber containing healthy control cells (top panel) or patients' cells (bottom panel). Representative for 4 patients.
Lack of polarization and chemotaxis of purified neutrophils toward a micropipette from which an optimal dose of fMLP is diffusing in a prewarmed chamber containing healthy control cells (top panel) or patients' cells (bottom panel). Representative for 4 patients.
These findings on adhesion and chemotaxis are surprising. We had previously found F-actin polymerization in neutrophils from the patient in family 1 to be completely normal upon cellular activation by various chemoattractants.1 Therefore, the inside-out signaling capacity through activation of Rap1 was tested in neutrophils, as well as in lymphocytes and platelets. As shown in Figure 4, no abnormalities were observed in the activation of Rap1.
Rap-1 activation in leukocytes and platelets of patients suffering from LAD-1/variant syndrome. TRAP indicates thrombin receptor-derived activation peptide. Representative for 5 patients.
Rap-1 activation in leukocytes and platelets of patients suffering from LAD-1/variant syndrome. TRAP indicates thrombin receptor-derived activation peptide. Representative for 5 patients.
There was active Rap present in the LAD-1/variant neutrophils (and platelets), also prior to stimulation, at equal levels as in control neutrophils, as demonstrated by blotting the same pull-down experiments with Rap1- or Rap2-specific antibodies (data not shown). In contrast to the time-dependent activation and deactivation of Rap1, Rap2 activity was stable and not subject to strong alterations in activity as in the case of the Rap1 activity shown in Figure 4. The data on Rap1 activation shown are representative for the results obtained with cells from 5 patients.
Moreover, in the purified granulocyte fractions, the major GEFs for Rap1 (ie, C3G and smg-GDS) were normally present on Western blots, with a similar molecular weight after gel electrophoresis when compared with the proteins blotted in lysates of control neutrophils. Epac (or cyclic AMP [cAMP]–GEF) was absent from both controls' and patients' neutrophils. Similar results were obtained for GAPs for Rap1, rap1GAPII, and SPA-1 (data not shown).
Together, these findings of normal Rap1 activation and identical amounts of the proteins involved in the GDP/GTP exchange of Rap1 in neutrophils from patients and controls render a defective Rap1 activity in these patients unlikely.
Zymosan activity
As previously described for the first patient,1 we have subsequently confirmed defective up-regulation of the activation epitope on CD11b/CD18 (CR3) as recognized by the MoAb CBRM1/5 in 3 additional patients. This effect was always corrected for the simultaneous up-regulation of CD11b, per se, as assessed by a normal nonconformational-constrained CD11b MoAb.
To avoid the intrinsic variability in the determination of activation epitopes, we have generated another test system that has been found to be reproducible and more robust. Unopsonized zymosan is used in the assay to induce uptake and NADPH oxidase activity in purified neutrophils. This test is based on the requirement for CR3 to change into its active conformation before unopsonized zymosan is taken up (Figure 5A) and the respiratory burst is initiated (Figure 5B).28 In control neutrophils, there is a lag time of about 10 to 12 minutes until the respiratory burst is initiated by unopsonized zymosan, probably reflecting the time needed for the neutrophils to become primed by the zymosan particles and CR3 to adopt its active high-affinity conformation for binding and uptake of zymosan. This response was absent in the neutrophils obtained from the LAD-1/variant patients (Figure 5C). Indeed, the lag time of normal neutrophils was very much shorter (< 3-5 minutes) when a high concentration of Mg2+ (10 mM) was added simultaneously with the zymosan, because this induces the active conformation of CR3 instantly (data not shown). In contrast to the STZ response, which we have never found to be defective in neutrophils from any of the patients tested, uptake and concomitant NADPH oxidase activity induced by bare, unopsonized zymosan was absent, even when measured over 60 to 90 minutes of incubation. Activation of CR3 by high Mg2+ concentrations resulted in uptake of zymosan, even in LAD-1/variant neutrophils, proving that CR3, once in its active conformation, is functional in these patients (Figure 5C). Altogether, the pattern of respiratory burst activity seen in the “zymosan test” makes it easy to discern the defective response with LAD-1/variant patients' neutrophils over a period of about 30 minutes in total.
Unopsonized zymosan uptake and activation of human neutrophils. (A) Neutrophil phagocytosis of zymosan is shown for neutrophils purified from a healthy donor (left panel) and a patient (right panel); in case of patient samples, particles were easily washed off during the preparation of cytospins because of the defective phagocytosis (n = 4 patients). (B) Neutrophils from a healthy control were stimulated with serum-treated zymosan (STZ) or unopsonized zymosan as described in “Patients, materials, and methods” (n > 100 controls). (C) Identical experiments with neutrophils from LAD-1/variant patients demonstrate the lack of NADPH oxidase activity in the absence of phagocytosis of the unopsonized zymosan particles (left bars; n = 12 controls and n = 5 patients [following similar procedures and timing], mean ± SD, at 10 minutes after addition of zymosan). The effect of simultaneous addition of Mg2+ and the zymosan particles indicates the potential to react in a CR3-dependent manner (right bars).
Unopsonized zymosan uptake and activation of human neutrophils. (A) Neutrophil phagocytosis of zymosan is shown for neutrophils purified from a healthy donor (left panel) and a patient (right panel); in case of patient samples, particles were easily washed off during the preparation of cytospins because of the defective phagocytosis (n = 4 patients). (B) Neutrophils from a healthy control were stimulated with serum-treated zymosan (STZ) or unopsonized zymosan as described in “Patients, materials, and methods” (n > 100 controls). (C) Identical experiments with neutrophils from LAD-1/variant patients demonstrate the lack of NADPH oxidase activity in the absence of phagocytosis of the unopsonized zymosan particles (left bars; n = 12 controls and n = 5 patients [following similar procedures and timing], mean ± SD, at 10 minutes after addition of zymosan). The effect of simultaneous addition of Mg2+ and the zymosan particles indicates the potential to react in a CR3-dependent manner (right bars).
In 4 families, we have shown this defective induction of NADPH oxidase activity by unopsonized zymosan in purified neutrophils from patients. In neutrophils from unaffected siblings, healthy parents, and controls, from all of whom blood was simultaneously drawn, shipped, and handled in the same way as the patients' blood samples, normal levels of neutrophil NADPH oxidase activity (as well as adhesion and chemotaxis) were found.
The dependence on the presence of functional CD11b/CD18 was further proven by the lack of NADPH oxidase activity as verified in 3 classical LAD-1 patients with known CD18 mutations and no CD11b/CD18 expression at all. Also, the addition of MoAb 44a, a blocking CD11b MoAb (10-minute preincubation at 10 μg/mL), completely prevented uptake and induction of NADPH oxidase activity by unopsonized zymosan particles, supporting the major role of CD11b/CD18 in this screening test (data not shown).
Mutation analysis of the CD18 gene was performed in all patients, with negative results. Other candidates contributing to inside-out signaling are cytohesins,29 L-plastin,30 talin,31 and the recently described RAPL.32 At the protein level, these molecules in the neutrophils from our patients were normally present, and their respective genes were without mutations (data not shown).
Discussion
The data from 9 patients in 7 unrelated families indicate that the LAD-1/variant syndrome can be recognized early in life by necrotic nonpussing lesions, poor wound healing, and a severe life-threatening bleeding tendency. Infections range from bacterial pneumonia and early septicemia to fungal disease. Severe intracranial hemorrhages may affect neonates, followed by a period of persistent mucosal bleeding and fragile gums due to chronic periodontitis during childhood. Three patients died: 1 patient died after BMT and graft failure and 2 died in the same family, 1 from pseudomonal septicemia during wound débridement and the other from a severe nose bleed after an unlucky fall from a staircase. Of the 2 patients who underwent transplantation, the case with the longest follow-up from his birth in 19921 has recently undergone transplantation successfully, demonstrating that BMT is curative.
There may be phenocopies of the syndrome with a different genetic background. Following our first case,1 a number of similar patients have been reported with defective LAD–Glanzmann-like syndrome.2-4 All these patients suffered from the typical complex of clinical features that were highly similar to the original patient we had described before (Table 1).
To date, several issues remain to be clarified. In vitro studies in the 3 reports on LAD–Glanzmann-like patients showed the involvement of the β1 integrin in 2 of the patients, as was defined by several test systems (Table 2). This may hold true for all cases of LAD-1/variant syndrome but only to variable degrees. The possibility of a β1 integrin dysfunction cannot be excluded, but, if present, it may be assumed to be subtle for multiple reasons. First, it seems not to be an apparent finding in the whole group of clinically identical patients, but this may depend on the tests performed1 (T.W.K., unpublished data, May 2004, October 2005, and January 2006). Second, β1 integrin involvement is expected to result in a more outspoken or lethal syndrome when these β1 integrin–dependent adhesive processes would also fail in the nonhematopoietic cells.33,34 The fact that the β3 integrins in platelets are involved without injury to the vasculature due to αvβ3 dysfunction makes us believe that the defect is largely restricted to the hematopoietic cell lineage. The successful BMT in one of the patients reinforces this notion. Finally, in the absence of β1 integrin function, a relatively normal hematopoiesis may be present,35 but lymphocyte trafficking would be severely affected when both the LFA-1 (CD11a/CD18) and VLA-4 (CD49d/CD29) integrins would be functionally impaired.36 Such a scenario, in which the integrin activation step to both β1 and β2 integrin function is strongly impaired, can be expected to result in a more severe combined immunodeficiency with recurrent or fatal viral and Pneumocystis jiroveci infections. CMV has been noted by us and by Harris et al2 during early infancy, but this did not result in severe disease or death. Severe viral disease was absent in our series of patients. The normal BCG vaccination responses also excluded serious cellular immune defects in the cytokine-activation loop involving IL-12 (and IL-23) and interferon-gamma (IFN-γ).37
Of interest, Alon and colleagues have suggested that the syndrome (called LAD-III by Kinashi et al5 ) is caused by an aberrant signaling of Rap1. This hypothesis would fit with the data on Rap1 activity in adhesion.6 In 1989, Kitayama38 was the first to describe Rap1 by its inhibition of the transforming activity of K-Ras. In 2001, Bos et al showed for the first time that Rap1 overcomes the active K-Ras effect by integrin function regulating adhesion and spreading, which was suggested to prevent transformation.6 Rap1 activation occurs in response to a variety of stimuli, including CD31 stimulation,39 T-cell receptor engagement,40 and chemokines.41
Rap1 has 2 isoforms, Rap1a and Rap1b, which differ in only a few amino acids. Rap1a/b are encoded by 2 Rap1 genes with more than 95% homology.6 The 2 Rap2 proteins are 65% homologous with the Rap1 proteins. While Rap1a proteins are ubiquitously expressed in tissues, Rap1b is the predominant Rap1 isoform and most abundant Ras family member in platelets.42 Recent gene deletion experiments have indicated that at least 40% of rap1b−/− murine embryos die due to bleedings in utero or perinatally,43 similar to the mouse integrin β3 subunit knock outs.44 The surviving rap1b-null mice were smaller but appeared otherwise normal, without overt hematologic defect or malignancy and with a normal lifespan. Bleeding time and platelet aggregation responses to various stimuli were abnormal. The reduced aggregation response was overcome at higher doses of collagen, which differs from the responses observed in the patients described in this study1 (T.W.K., unpublished observations, October 2005 and January 2006). Rap1a activity is undetectable in platelets, and rap1a-null platelets show normal aggregation.43 Finally, Rap2 is present in human neutrophils.12 Its activity and function are not exactly known,41,45,46 but seem unaffected by chemokines or other forms of activation (N.K., D.R., T.W.K., unpublished observations, March and May 2004, February and October 2005).
In conclusion, apart from the findings in a single Epstein-Barr virus (EBV)–transformed B-cell line from the patient described by the group of Alon (Kinashi et al5 ), there is little evidence for defective Rap1 activation in any of the patients described thus far with the LAD-1/variant syndrome.
The molecular defect in LAD-1/variant syndrome is as yet unknown. Many molecules involved in signal transduction have been identified in regulating integrin activity, but only limited evidence exists on the signaling pathways that control the inside-out signaling. In this respect, the Rho family GEF Vav1 is of interest.47,48 There are 3 homologues that become activated via membrane recruitment and phosphorylation by Src or Syk tyrosine kinases. However, Vav was normally expressed in our patients on Western blotting, as also reported by McDowall et al,3 and showed normal phosphorylation upon neutrophil activation (data not shown). Also, the upstream kinase Syk is unlikely because of the normal neutrophil migration in vitro and in vivo in murine syk−/− bone marrow chimeras,49 together with our findings on normal Vav and phospho-Vav in patients' neutrophils. Candidate actin-binding integrin partners, such as talin, filamin, and calreticulin, associate with all the activation-impaired leukocyte and platelet integrins.31,50,51 Although these key integrin adaptors are not restricted to cells of the hematopoietic lineage, it remains possible that homologous cell-specific adaptors may be defective in LAD-1/variant syndrome.
The LAD-1/variant syndrome can be easily defined by a simple screening test as described in this paper, instead of using the detection of activation epitopes as experimental evidence. The latter test has been found not sufficiently sensitive and highly variable, and hence, it cannot be used as the gold standard. The important advantage of the present screening test with respect to sensitivity and reproducibility is a large diagnostic improvement. In the presence of normal β2 integrin expression levels on all leukocytes and normal up-regulation of these integrins upon activation on neutrophils, but abnormal neutrophil chemotaxis, the zymosan test applied is robust and can easily discriminate the functional defect of such patients (Table 2).
The test is based on the lack of activation of CR3 in LAD-1/variant neutrophils in response to an external stimulus (ie, unopsonized bare zymosan). While in neutrophils from healthy controls, CR3 is activated over a period of 10 to 12 minutes in response to the presence of zymosan, leading to uptake of the particle and NADPH oxidase activation; this activation is not seen in LAD-1/variant neutrophils. The nature of the signal that leads to CR3 activation is not clear. Vetvicka et al52 described the involvement of the lectin site in CD11b in priming of the receptor, while also TLR2 and Dectin-1 can respond to zymosan and are present on neutrophils. TLRs have been described before to be able to activate CR3 in response to pathogens,53 and are therefore good candidates to take part in the activation of CR3 in the zymosan test. Dectin-1 is also a very interesting molecule in this respect, as it has been shown to function as a phagocytic receptor for zymosan in mice, independent of integrins.54 However, from our results and previous reports,55 it is apparent that CR3 is indispensable for the uptake of zymosan by human neutrophils.
In conclusion, the study of all the molecules that may be involved in integrin activation was based on an educated guess about the causative gene defect. Family studies will be required for genetic linkage analysis. The availability of a good screening test makes the diagnosis of patients suffering from an identical syndrome easier and may help to pin down the defect.
Authorship
Conflict-of-interest disclosure: The authors declare no competing financial interests.
Correspondence: T. W. Kuijpers, Emma Children's Hospital, Academic Medical Center (Rm G8-205), Meibergdreef 9, 1105 AZ Amsterdam, the Netherlands; e-mail: t.w.kuijpers@amc.uva.nl.
The online version of this manuscript contains a data supplement.
An Inside Blood analysis of this article appears at the front of this issue.
The publication costs of this article were defrayed in part by page charge payment. Therefore, and solely to indicate this fact, this article is hereby marked “advertisement” in accordance with 18 USC section 1734.
This work was financially supported by the Landsteiner Foundation for Blood Transfusion Research.
We are grateful to Drs A. Metin, S. Berrak, and E. Ozek for their help and collaboration in our studies. We thank Drs K. Reedquist and J. Bos for their helpful suggestions.





![Figure 5. Unopsonized zymosan uptake and activation of human neutrophils. (A) Neutrophil phagocytosis of zymosan is shown for neutrophils purified from a healthy donor (left panel) and a patient (right panel); in case of patient samples, particles were easily washed off during the preparation of cytospins because of the defective phagocytosis (n = 4 patients). (B) Neutrophils from a healthy control were stimulated with serum-treated zymosan (STZ) or unopsonized zymosan as described in “Patients, materials, and methods” (n > 100 controls). (C) Identical experiments with neutrophils from LAD-1/variant patients demonstrate the lack of NADPH oxidase activity in the absence of phagocytosis of the unopsonized zymosan particles (left bars; n = 12 controls and n = 5 patients [following similar procedures and timing], mean ± SD, at 10 minutes after addition of zymosan). The effect of simultaneous addition of Mg2+ and the zymosan particles indicates the potential to react in a CR3-dependent manner (right bars).](https://ash.silverchair-cdn.com/ash/content_public/journal/blood/109/8/10.1182_blood-2006-05-021402/4/m_zh80080710930005.jpeg?Expires=1765996005&Signature=ijdQJF0rfj-vxbdFvlRT6WoePACrTXoCcWV9FSNEyuWlYY0cCG~m1Vx5VBoZ6bRVFDlvCcnRFnsi3-xRtjMRaqUlqRmwEF0XggccHR0y7RMeKKsF~lhSf6JwUylA8uGeh0f2N4whEjwN68bagXSpprixmnSzVu5s0Cbz9gBOvb0ykhC4SqFlda0LCpenO~RvRTfk7STwsiK94Pq~CrQ5rY12ReTlTiWsZ9y8OEdMLUbp7iPma7vjGP4zPMma~NOGT9cGFrx9N0XRZGiY9hlNwYGkomrrc9O3aDPZL4PkhF6CJO3jT7NXpp2CDpvDY0YEnKaof4UT89bue-S-nbMaSQ__&Key-Pair-Id=APKAIE5G5CRDK6RD3PGA)

![Figure 5. Unopsonized zymosan uptake and activation of human neutrophils. (A) Neutrophil phagocytosis of zymosan is shown for neutrophils purified from a healthy donor (left panel) and a patient (right panel); in case of patient samples, particles were easily washed off during the preparation of cytospins because of the defective phagocytosis (n = 4 patients). (B) Neutrophils from a healthy control were stimulated with serum-treated zymosan (STZ) or unopsonized zymosan as described in “Patients, materials, and methods” (n > 100 controls). (C) Identical experiments with neutrophils from LAD-1/variant patients demonstrate the lack of NADPH oxidase activity in the absence of phagocytosis of the unopsonized zymosan particles (left bars; n = 12 controls and n = 5 patients [following similar procedures and timing], mean ± SD, at 10 minutes after addition of zymosan). The effect of simultaneous addition of Mg2+ and the zymosan particles indicates the potential to react in a CR3-dependent manner (right bars).](https://ash.silverchair-cdn.com/ash/content_public/journal/blood/109/8/10.1182_blood-2006-05-021402/4/m_zh80080710930005.jpeg?Expires=1766601010&Signature=LUltgSDMlOkXQQhoe0jjaS5so8H~Uexf7Bu7AtTlV9t2A3G16ZR7UHxQd~do11u747ToftMMOkno798pXddgZb6aGk2g9aqt3cKwEbyuCud18DosSsYt5SKsSBsPhmE9PnW6S4L8uTEc3GHiNEbXf9C4ZVMdDfJSwtLJsBneDWQ1IZpKQ2HChZ15DBewpli6as7hTlgy4vN09WjtTdgp5rqofu58cA~cwoUxljiHpBcPFezPTKIGj62kFbfY~B6i7mbQ2eUhPxD8SwKMUEvF2S-xPnEXYpkv~jTSP6yGXG9DZmxCD2xfg-2zLvrN4AgFeTmb7pUxchd1AOaxVwUUxA__&Key-Pair-Id=APKAIE5G5CRDK6RD3PGA)